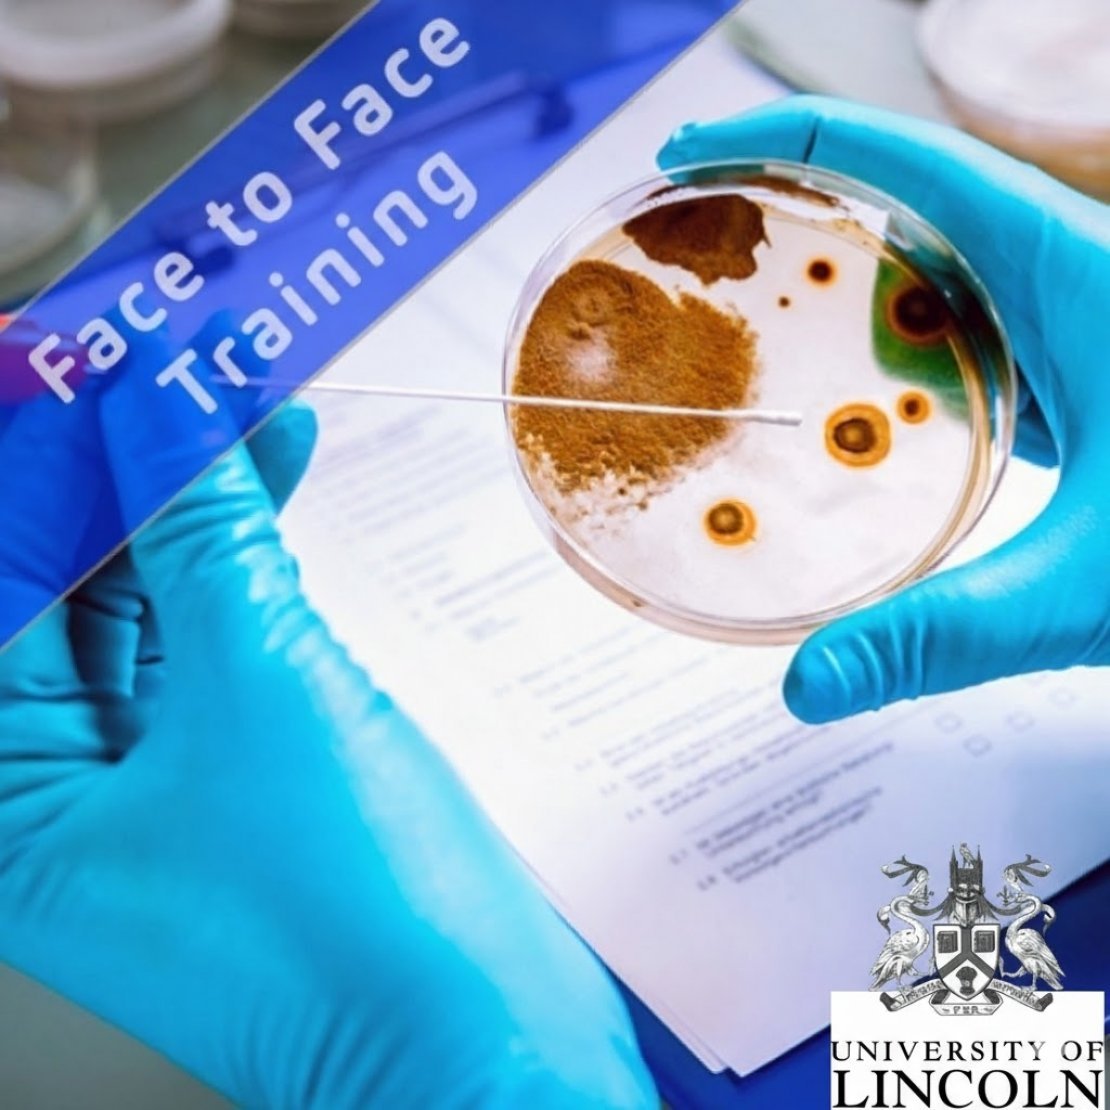
L4 Principles of Microbiology

The 2025 training programme includes a wide portfolio of available courses. Most courses are delivered via Microsoft Teams ('Virtual Training Courses'), while some courses are 'Face to Face' and are being held either at Kersia UK Head Office in Bury, Campden BRI Chipping Campden or other locations in the UK and Ireland.
The training shop enables you to view and/or book a place on one of our advertised training courses if places are available. You can download all the course details from the shop without purchase. You can book one or more places on a course and if known, when booking, give delegate names and any special requirements.